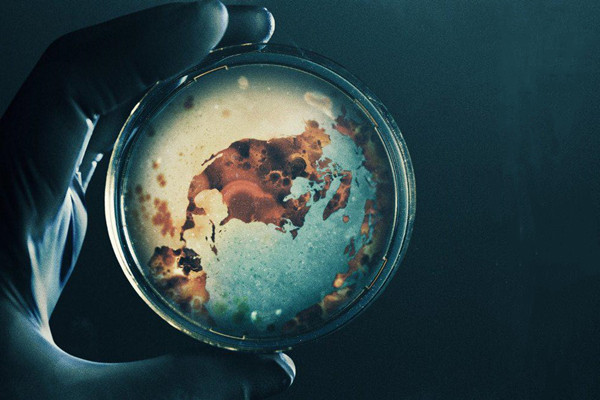

作为“大讲堂艺术影院”系列展映活动的首场影片,12月12日下午,电影《看不见的敌人》在百周年纪念讲堂观众厅上映。该片是2017年首映于美国有线电视新闻网的一部科普性纪录片,影片从医生、患者家属、科研人员、幸存者的不同视角,带观众了解了新闻报道之外关于埃博拉、流感和寨卡这三种病毒更多触动人心的细节。“It’s really we act now or pay later.”影片警示我们,在病毒日益威胁人类生存的同时,我们对它的认识和防备却远远不足。流行病不是简单的疾病或者死亡,其背后是相互依存着的科学、政府、公众之间的和解与博弈。
从今年新冠疫情席卷全球的视角回望这部电影,很容易发现它的前瞻性和启发性。尤其是片中关于蝙蝠作为病毒宿主和活禽交易传播病毒的讨论,在逆向选择之下它们几如谶语。人类文明高速发展的同时也对自然造成了侵蚀,并为病毒带来了更多感染人类和广泛传播的机会。新冠疫情并不是流行病爆发的孤立事件,所谓的猝不及防仅仅是因为人们对病毒缺乏应有的关注。当救护车接连来到早已超负荷运转的医疗点,当正是花样年华的女孩在几天之内被夺去生命,当小头症婴儿的患例骤然增加……因为意识到得太晚,人们为之付出了惨痛的代价。“Outbreaks are inevitable, pandemics are optional.”也许爆发不可避免,但及时控制、避免蔓延一定是取决于我们每一个人的选择。

从专业性的角度来看,影片《看不见的敌人》无疑是有欠缺的。无论是关于病毒来源和变异性的讨论,还是关于疫苗原理、安全性和有效性的分析,抑或是对医学伦理和公共卫生方面的思考,它都只是浅尝辄止。因此,片中给出的许多观点和建议也浮于表面,缺乏说服力。另外,影片选择特定个人的经历作为重点内容,虽增加了感染力,但也丧失了一定的普遍性。尽管如此,这部记录片仍然值得一看。毕竟我们对病毒了解得太少,哪怕多知道一点都有所助益。

在黑天鹅事件发生的当下,我们很难不为新冠疫情的爆发感到迷茫和困惑。所有人都期待着一个答案能够浮出水面,一语定论。只是,影片《看不见的敌人》做不到这一点,也许谁都不能。当既没有尖牙利爪,又没有庞然身型的人类通过演化的捷径早早登上食物链的顶端,不知所措的不只是下游的其他生物,更是人类自己。在自外于大自然的道路上,人们已经走得太远,而不知道未来该去向何方。气候变化、瘟疫频发、不可再生能源持续消耗……也许科技的发展可以给出这些问题的解决方案,但是我们同时也应该重新思考:我们到底从哪里来,现在正在何处,以及我们为什么在这里。
2020年,虽然曾经非典时代的记忆已经逐渐远去,新冠的出现又提醒人们,就对病毒和瘟疫的了解而言,我们还只是刚刚在路上。“见兔而顾犬,未为晚也;亡羊则补牢,未为迟也。”也许,应对一场流行病最好的时间是在爆发之前,其次就是现在。
编辑:张珏、张曼罗



